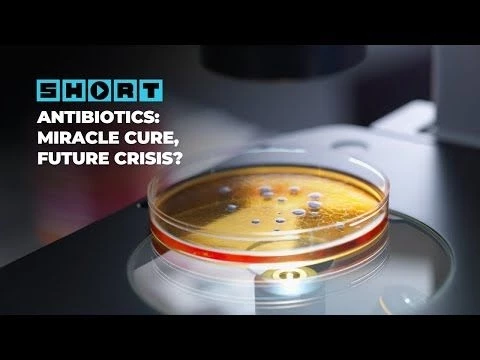
The Rise of Antibiotic Resistance

The Rise of Antibiotic Resistance
1 month
0 Views
Controls Mode:
Normal Controls
Disable All Controls
Basic Controls Only
Hide Progress Bar & Prevent Pause
Category:
Description:
Antibiotics have been one of humanity's most powerful tools in the fight against infectious disease. But there's a pretty big catch.
